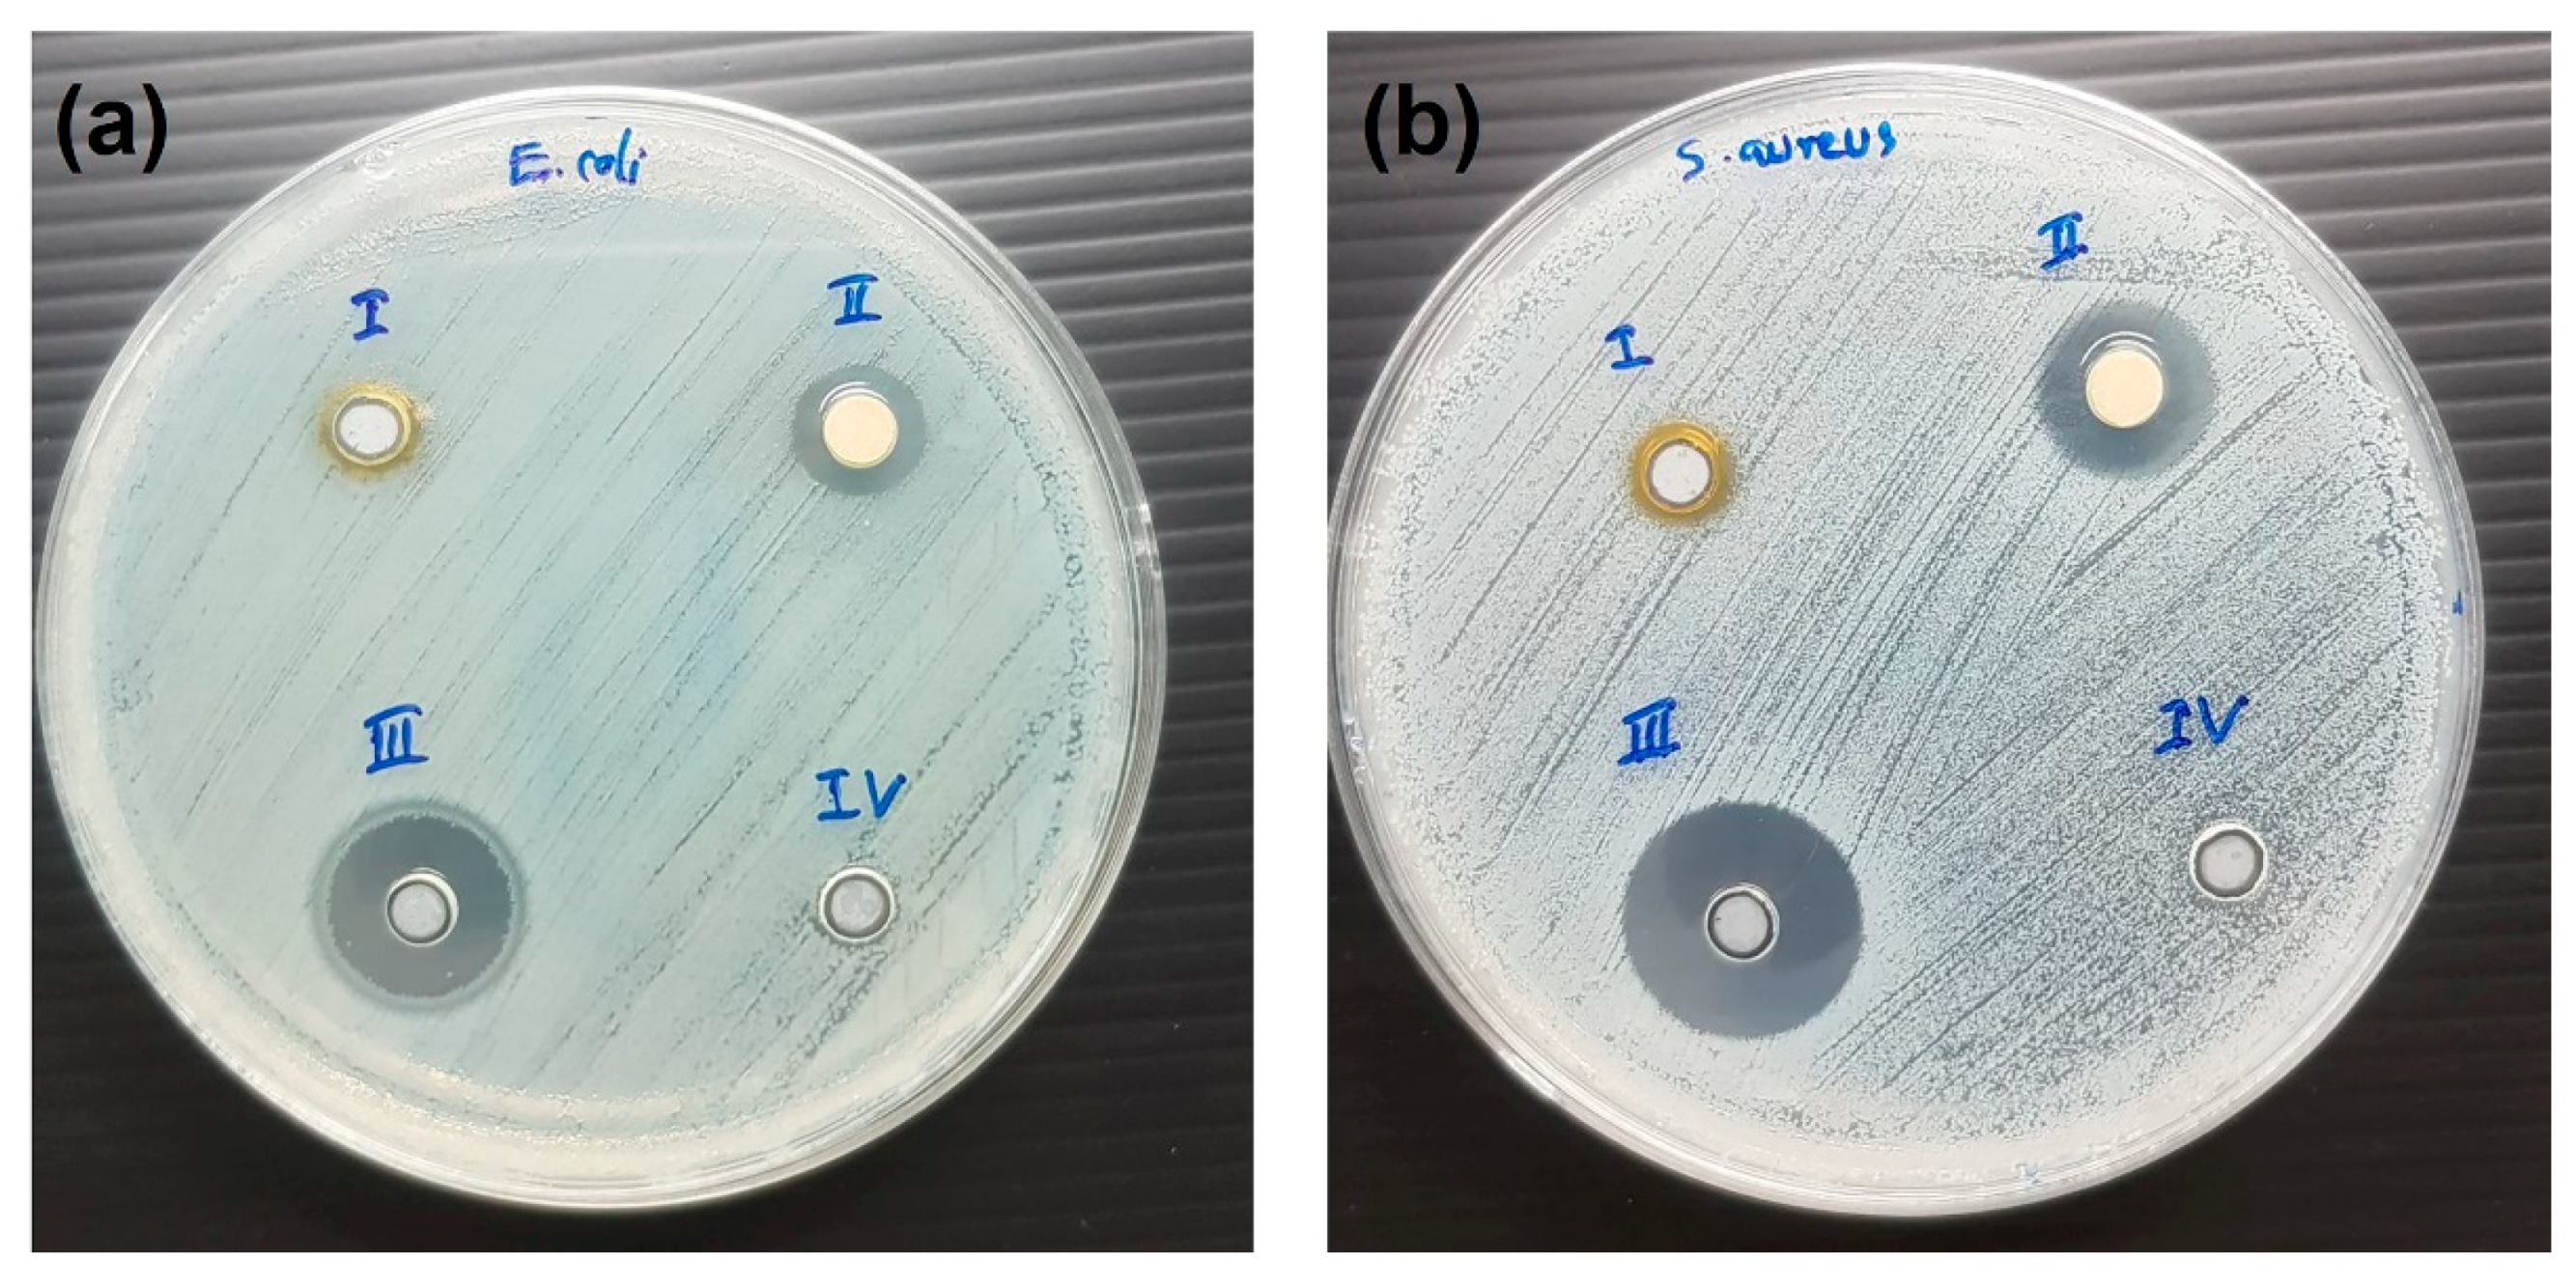
Nanomaterials 11 00442 g007 Nanomaterials 11 00442 g007

The Decoration of ZnO Nanoparticles by Gamma Aminobutyric Acid, Curcumin Derivative and Silver Nanoparticles: Synthesis, Characterization and Antibacterial Evaluation
Abstract
1. Introduction
2. Materials and Methods
2.1. Materials
2.2. Methods
2.2.1. Synthesis of CurBF2
2.2.2. Synthesis of γ-Aminobutyric Acid-Capped ZnO NPs (ZnO NPs-GABA)
2.2.3. Functionalization of CurBF2 on ZnO NPs-GABA
2.2.4. The synthesis of Silver Nanoparticles (CurBF2-AgNPs) and Their Decoration on ZnO NPs-GABA
2.2.5. Bacteria Strains Preparation
2.2.6. Antibacterial Screening by Well Diffusion
2.2.7. Minimum Inhibitory Concentrations (MICs) by Broth Microdilution Method
2.2.8. Characterization Methods
3. Results and Discussion
3.1. ZnO Nanoparticles Functionalization by γ-Aminobutyric Acid (GABA) and CurBF2 and the Decoration of CurBF2 on ZnO NPs
3.2. Morphological Analysis of the ZnO Nanostructures
3.3. Zeta Potential
3.4. Dynamic Light Scattering
3.5. Crystallinity of ZnO Nanostructures
3.6. Surface Functional Group Analysis
3.7. The Photophysical Properties of ZnO Nanostructures
3.7.1. UV–VIS Diffuse Reflectance Spectra
3.7.2. Fluorescence Spectra
3.8. Antibacterial Activity
3.8.1. Inhibition Zone Method
3.8.2. Minimum Inhibitory Concentration (MIC) Determination
4. Conclusions
Supplementary Materials
Author Contributions
Funding
Data Availability Statement
Acknowledgments
Conflicts of Interest
References
- Mirhosseini, M.; Firouzabadi, F.B. Antibacterial activity of zinc oxide nanoparticle suspensions on food-borne pathogens. Int. J. Dairy Technol. 2013, 66, 291–295. [Google Scholar] [CrossRef]
- Padmavathy, N.; Vijayaraghavan, R. Enhanced bioactivity of ZnO nanoparticles-an antimicrobial study. Sci. Technol. Adv. Mater. 2008, 9, 035004. [Google Scholar] [CrossRef] [PubMed]
- Raghupathi, K.R.; Koodali, R.T.; Manna, A.C. Size-Dependent Bacterial Growth Inhibition and Mechanism of Antibacterial Activity of Zinc Oxide Nanoparticles. Langmuir 2011, 27, 4020–4028. [Google Scholar] [CrossRef]
- Buzea, C.; Pacheco, I.I.; Robbie, K. Nanomaterials and nanoparticles: Sources and toxicity. Biointerphases 2007, 2, MR17–MR71. [Google Scholar] [CrossRef]
- Seil, J.T.; Webster, T.J. Antimicrobial applications of nanotechnology: Methods and literature. Int. J. Nanomed. 2012, 7, 2767–2781. [Google Scholar] [CrossRef]
- Xie, Y.; He, Y.; Irwin, P.L.; Jin, T.; Shi, X. Antibacterial activity and mechanism of action of zinc oxide nanoparticles against Campylobacter jejuni. Appl. Environ. Microbiol. 2011, 77, 2325–2331. [Google Scholar] [CrossRef]
- Sawai, J. Quantitative evaluation of antibacterial activities of metallic oxide powders (ZnO, MgO and CaO) by conductimetric assay. J. Microbiol. Methods 2003, 54, 177–182. [Google Scholar] [CrossRef]
- Ghaffari, S.-B.; Sarrafzadeh, M.-H.; Fakhroueian, Z.; Shahriari, S.; Khorramizadeh, M.R. Functionalization of ZnO nanoparticles by 3-mercaptopropionic acid for aqueous curcumin delivery: Synthesis, characterization, and anticancer assessment. Mater. Sci. Eng. C 2017, 79, 465–472. [Google Scholar] [CrossRef]
- Xu, C.; Yang, C.; Gu, B.; Fang, S. Nanostructured ZnO for biosensing applications. Chin. Sci. Bull. 2013, 58, 2563–2566. [Google Scholar] [CrossRef]
- Safaei-Ghomi, J.; Ghasemzadeh, M.A. Zinc oxide nanoparticles: A highly efficient and readily recyclable catalyst for the synthesis of xanthenes. Chin. Chem. Lett. 2012, 23, 1225–1229. [Google Scholar] [CrossRef]
- Nageswara Rao, T.; Apparao, K.; Murthy, S.N.V.S.; Manohara Naidu, T. Applications of Zinc oxide Nanoparticles as Catalyst in Dissipation Kinetics of S-Metolachlor Herbicide in Different pH waters UnderDirect sun light. Mater. Today Proc. 2016, 3, 3799–3804. [Google Scholar] [CrossRef]
- Kakarndee, S.; Nanan, S. SDS capped and PVA capped ZnO nanostructures with high photocatalytic performance toward photodegradation of reactive red (RR141) azo dye. J. Environ. Chem. Eng. 2018, 6, 74–94. [Google Scholar] [CrossRef]
- Chankhanittha, T.; Watcharakitti, J.; Nanan, S. PVP-assisted synthesis of rod-like ZnO photocatalyst for photodegradation of reactive red (RR141) and Congo red (CR) azo dyes. J. Mater. Sci. Mater. Electron. 2019, 30, 17804–17819. [Google Scholar] [CrossRef]
- Zhang, Z.-Y.; Xiong, H.-M. Photoluminescent ZnO nanoparticles and their biological applications. Materials 2015, 8, 3101–3127. [Google Scholar] [CrossRef]
- Yahya, N.; Daud, H.; Tajuddin, N.; Daud, H.; Shafie, A.; Puspitasari, P. Application of ZnO Nanoparticles EM Wave Detector Prepared by Sol-Gel and Self-Combustion Techniques. J. Nano Res. J. Nano Res. 2010, 11, 25–34. [Google Scholar] [CrossRef]
- Ali, A.; Phull, A.-R.; Zia, M. Elemental zinc to zinc nanoparticles: Is ZnO NPs crucial for life? Synthesis, toxicological, and environmental concerns. Nanotechnol. Rev. 2018, 7, 413–441. [Google Scholar] [CrossRef]
- Wojnarowicz, J.; Chudoba, T.; Lojkowski, W. A Review of Microwave Synthesis of Zinc Oxide Nanomaterials: Reactants, Process Parameters and Morphologies. Nanomaterials 2020, 10, 1086. [Google Scholar] [CrossRef] [PubMed]
- Chimanpure, J.; Ashtaputre, S.; Marathe, S.; Hebalkar, N.; Kharrazi, S.; Pasricha, R.; Kulkarni, S.K. Synthesis and Characterization of Mercaptoethanol Capped Zinc Oxide Nanoparticles Capped with Organic Molecules. Synth. React. Inorg. Met. Org. Nano-Met. Chem. 2006, 36, 65–69. [Google Scholar] [CrossRef]
- Saravanan, P.; Jayamoorthy, K.; Ananda Kumar, S. Switch-On fluorescence and photo-induced electron transfer of 3-aminopropyltriethoxysilane to ZnO: Dual applications in sensors and antibacterial activity. Sens. Actuators B Chem. 2015, 221, 784–791. [Google Scholar] [CrossRef]
- Liao, Y.; Hu, Z.; Gu, Q.; Xue, C. Amine-Functionalized ZnO Nanosheets for Efficient CO2 Capture and Photoreduction. Molecules 2015, 20, 18847–18855. [Google Scholar] [CrossRef]
- Fakhroueian, Z.; Harsini, F.; Chalabian, F.; Katouzian, F.; Shafiekhani, A.; Esmaeilzadeh, P. Influence of Modified ZnO Quantum Dots and Nanostructures as New Antibacterials. Adv. Nanoparticles 2013, 2, 247–258. [Google Scholar] [CrossRef]
- Zhuang, J.; Liu, M.; Liu, H. MAA-modified and luminescence properties of ZnO quantum dots. Sci. China Ser. B-Chem. 2009, 52, 2125. [Google Scholar] [CrossRef]
- Kim, K.-E.; Kim, T.G.; Sung, Y.-M. Enzyme-conjugated ZnO nanocrystals for collisional quenching-based glucose sensing. CrystEngComm 2012, 14, 2859–2865. [Google Scholar] [CrossRef]
- Ray, P.G.; Biswas, S.; Roy, T.; Ghosh, S.; Majumder, D.; Basak, P.; Roy, S.; Dhara, S. Sonication Assisted Hierarchical Decoration of Ag-NP on Zinc Oxide Nanoflower Impregnated Eggshell Membrane: Evaluation of Antibacterial Activity and in Vitro Cytocompatibility. ACS Sustain. Chem. Eng. 2019, 7, 13717–13733. [Google Scholar] [CrossRef]
- Shakerimoghaddam, A.; Razavi, D.; Rahvar, F.; Khurshid, M.; Ostadkelayeh, S.M.; Esmaeili, S.-A.; Khaledi, A.; Eshraghi, M. Evaluate the Effect of Zinc Oxide and Silver Nanoparticles on Biofilm and icaA Gene Expression in Methicillin-Resistant Staphylococcus aureus Isolated From Burn Wound Infection. J. Burn Care Res. 2020, 41, 1253–1259. [Google Scholar] [CrossRef]
- Kinnersley, A.M.; Turano, F.J. Gamma Aminobutyric Acid (GABA) and Plant Responses to Stress. Crit. Rev. Plant Sci. 2000, 19, 479–509. [Google Scholar] [CrossRef]
- Wu, C.; Sun, D. GABA receptors in brain development, function, and injury. Metab. Brain Dis. 2015, 30, 367–379. [Google Scholar] [CrossRef] [PubMed]
- Patterson, E.; Ryan, P.M.; Wiley, N.; Carafa, I.; Sherwin, E.; Moloney, G.; Franciosi, E.; Mandal, R.; Wishart, D.S.; Tuohy, K.; et al. Gamma-aminobutyric acid-producing lactobacilli positively affect metabolism and depressive-like behaviour in a mouse model of metabolic syndrome. Sci. Rep. 2019, 9, 16323. [Google Scholar] [CrossRef]
- Abdeldaiem, M.H. Use of Yellow Pigment Extracted from Turmeric (Curcuma Longa) Rhizomes Powder as Natural Food Preservative. Am. J. Food Sci. Technol. 2014, 2, 36–47. [Google Scholar] [CrossRef]
- Akbik, D.; Ghadiri, M.; Chrzanowski, W.; Rohanizadeh, R. Curcumin as a wound healing agent. Life Sci. 2014, 116, 1–7. [Google Scholar] [CrossRef]
- Mishra, S.; Palanivelu, K. The effect of curcumin (turmeric) on Alzheimer’s disease: An overview. Ann. Indian Acad. Neurol. 2008, 11, 13–19. [Google Scholar] [CrossRef] [PubMed]
- Hodaei, H.; Adibian, M.; Nikpayam, O.; Hedayati, M.; Sohrab, G. The effect of curcumin supplementation on anthropometric indices, insulin resistance and oxidative stress in patients with type 2 diabetes: A randomized, double-blind clinical trial. Diabetol. Metab. Syndr. 2019, 11, 41. [Google Scholar] [CrossRef]
- Burge, K.; Gunasekaran, A.; Eckert, J.; Chaaban, H. Curcumin and Intestinal Inflammatory Diseases: Molecular Mechanisms of Protection. Int. J. Mol. Sci. 2019, 20, 1912. [Google Scholar] [CrossRef] [PubMed]
- Dai, Q.; Zhou, D.; Xu, L.; Song, X. Curcumin alleviates rheumatoid arthritis-induced inflammation and synovial hyperplasia by targeting mTOR pathway in rats. Drug Des. Dev. Ther. 2018, 12, 4095–4105. [Google Scholar] [CrossRef] [PubMed]
- Chaicham, A.; Kulchat, S.; Tumcharern, G.; Tuntulani, T.; Tomapatanaget, B. Synthesis, photophysical properties, and cyanide detection in aqueous solution of BF2-curcumin dyes. Tetrahedron 2010, 66, 6217–6223. [Google Scholar] [CrossRef]
- Moussawi, R.N.; Patra, D. Modification of nanostructured ZnO surfaces with curcumin: Fluorescence-based sensing for arsenic and improving arsenic removal by ZnO. RSC Adv. 2016, 6, 17256–17268. [Google Scholar] [CrossRef]
- Talodthaisong, C.; Boonta, W.; Thammawithan, S.; Patramanon, R.; Kamonsutthipaijit, N.; Hutchison, J.A.; Kulchat, S. Composite guar gum-silver nanoparticle hydrogels as self-healing, injectable, and antibacterial biomaterials. Mater. Today Commun. 2020, 24, 100992. [Google Scholar] [CrossRef]
- Paramelle, D.; Sadovoy, A.; Gorelik, S.; Free, P.; Hobley, J.; Fernig, D.G. A rapid method to estimate the concentration of citrate capped silver nanoparticles from UV-visible light spectra. Analyst 2014, 139, 4855–4861. [Google Scholar] [CrossRef]
- Siritongsuk, P.; Hongsing, N.; Thammawithan, S.; Daduang, S.; Klaynongsruang, S.; Tuanyok, A.; Patramanon, R. Two-Phase Bactericidal Mechanism of Silver Nanoparticles against Burkholderia pseudomallei. PLoS ONE 2016, 11, e0168098. [Google Scholar] [CrossRef]
- Kanthawong, S.; Bolscher, J.G.M.; Veerman, E.C.I.; van Marle, J.; de Soet, H.J.J.; Nazmi, K.; Wongratanacheewin, S.; Taweechaisupapong, S. Antimicrobial and antibiofilm activity of LL-37 and its truncated variants against Burkholderia pseudomallei. Int. J. Antimicrob. Agents 2012, 39, 39–44. [Google Scholar] [CrossRef]
- Saenchoopa, A.; Boonta, W.; Talodthaisong, C.; Srichaiyapol, O.; Patramanon, R.; Kulchat, S. Colorimetric detection of Hg(II) by γ-aminobutyric acid-silver nanoparticles in water and the assessment of antibacterial activities. Spectrochim. Acta Part A: Mol. Biomol. Spectrosc. 2021, 251, 119433. [Google Scholar] [CrossRef]
- Ghaffari, S.B.; Moghaddam, J. Precipitation of various shapes of nanosized zinc oxide from zinc chloride solutions by neutralization with MgO and Ca(OH)2 as non-transparent basic agents. J. Iran. Chem. Soc. 2012, 9, 687–692. [Google Scholar] [CrossRef]
- Liu, Y.; Kou, Q.; Xing, S.; Mao, C.; Naveen, K.; Han, Q.; Song, J.; Liu, H.; Liu, Y.; Yan, Y.; et al. Structural, Magnetic and Optical Properties in V Doped ZnO Nanoparticles by Sol–Gel Method. Nanosci. Nanotechnol. Lett. 2015, 7, 1–6. [Google Scholar] [CrossRef]
- Adhikari, S.; Banerjee, A.; KrishnaRao Eswar, N.; Sarkar, D.; Madras, G. Photocatalytic inactivation of E. Coli by ZnO–Ag nanoparticles under solar radiation. RSC Adv. 2015, 5, 51067–51077. [Google Scholar] [CrossRef]
- Bhushan, B.; Murty, B.S.; Mondal, K. A new approach for synthesis of ZnO nanorod flowerets and subsequent pure free-standing ZnO nanorods. Adv. Powder Technol. 2019, 30, 30–41. [Google Scholar] [CrossRef]
- Kim, K.-M.; Choi, M.-H.; Lee, J.-K.; Jeong, J.; Kim, Y.-R.; Kim, M.-K.; Paek, S.-M.; Oh, J.-M. Physicochemical properties of surface charge-modified ZnO nanoparticles with different particle sizes. Int. J. Nanomed. 2014, 9 (Suppl. 2), 41–56. [Google Scholar] [CrossRef]
- Becker, J.; Raghupathi, K.R.; St Pierre, J.; Zhao, D.; Koodali, R.T. Tuning of the Crystallite and Particle Sizes of ZnO Nanocrystalline Materials in Solvothermal Synthesis and Their Photocatalytic Activity for Dye Degradation. J. Phys. Chem. C 2011, 115, 13844–13850. [Google Scholar] [CrossRef]
- Mukherjee, S.; Chowdhury, D.; Kotcherlakota, R.; Patra, S.; Vinothkumar, B.; Bhadra, M.P.; Sreedhar, B.; Patra, C.R. Potential theranostics application of bio-synthesized silver nanoparticles (4-in-1 system). Theranostics 2014, 4, 316–335. [Google Scholar] [CrossRef]
- Mishra, D.S.; Srivastava, R.; Prakash, S. Photoluminescence and Photoconductivity Studies of ZnO Nanoparticles Prepared by Solid State Reaction Method. J. Mater. Sci. Mater. Electron. 2012, 24, 125–134. [Google Scholar] [CrossRef]
- Šimšíková, M.; Antalík, M.; Kaňuchová, M.; Škvarla, J. Anionic 11-mercaptoundecanoic acid capped ZnO nanoparticles. Appl. Surf. Sci. 2013, 282, 342–347. [Google Scholar] [CrossRef]
- Nagaraju, G.; Udayabhanu, S.; Prashanth, S.A.; Shastri, M.; Yathish, K.V.; Anupama, C.; Rangappa, D. Electrochemical heavy metal detection, photocatalytic, photoluminescence, biodiesel production and antibacterial activities of Ag–ZnO nanomaterial. Mater. Res. Bull. 2017, 94, 54–63. [Google Scholar] [CrossRef]
- Saikia, L.; Bhuyan, D.; Saikia, M.; Malakar, B.; Dutta, D.K.; Sengupta, P. Photocatalytic performance of ZnO nanomaterials for self sensitized degradation of malachite green dye under solar light. Appl. Catal. A Gen. 2015, 490, 42–49. [Google Scholar] [CrossRef]
- Musa, I.; Qamhieh, N.; Mahmoud, S.T. Synthesis and length dependent photoluminescence property of zinc oxide nanorods. Results Phys. 2017, 7, 3552–3556. [Google Scholar] [CrossRef]
- Venkatesan, G.; Vijayaraghavan, R.; Chakravarthula, S.N.; Sathiyan, G. Fluorescent zinc oxide nanoparticles of Boswellia ovalifoliolata for selective detection of picric acid. Front. Res. Today 2019, 2, 2002. [Google Scholar] [CrossRef]
- Ferreyra Maillard, A.P.V.; Gonçalves, S.; Santos, N.C.; López de Mishima, B.A.; Dalmasso, P.R.; Hollmann, A. Studies on interaction of green silver nanoparticles with whole bacteria by surface characterization techniques. Biochim. Biophys. Acta Biomembr. 2019, 1861, 1086–1092. [Google Scholar] [CrossRef]
- Yamamoto, O. Influence of particle size on the antibacterial activity of zinc oxide. Int. J. Inorg. Mater. 2001, 3, 643–646. [Google Scholar] [CrossRef]
- Sawai, J.; Kawada, E.; Kanou, F.; Igarashi, H.; Hashimoto, A.; Kokugan, T.; Shimizu, M. Detection of active oxygen generated from ceramic powders having antibacterial activity. J. Chem. Eng. Jpn. 1996, 29, 627–633. [Google Scholar] [CrossRef]

| Nanoparticles | Spheres (nm) | Rods | |
|---|---|---|---|
| Diameter (nm) | Length (nm) | ||
| ZnO NPs | 76.40 ± 16.31 | - | - |
| ZnO NPs-GABA | 31.75 ± 10.42 | 31.36 ± 9.13 | 139.24 ± 38.72 |
| ZnO NPs-GABA-CurBF2 | 53.46 ± 14.60 | 56.54 ± 12.00 | 141.44 ± 47.57 |
| Bacteria | Zone of Inhibition (mm) | ||
|---|---|---|---|
| ZnO NPs-GABA/CurBF2-AgNPs | CurBF2-AgNPs | Gentamicin | |
| E. coli | 10.17 ± 0.24 | 0.00 ± 0.00 | 14.00 ± 1.00 |
| S. aureus | 13.50 ± 0.41 | 7.33 ± 0.29 | 18.00 ± 0.50 |
| Agents | Gram-Positive Bacteria | Gram-Negative Bacteria |
|---|---|---|
| S. aureus | E. coli | |
| MIC (µg/mL) | MIC (µg/mL) | |
| ZnO NPs | 100 | n.d. |
| ZnO NPs-GABA | 100 | 200 |
| ZnO NPs-GABA-CurBF₂ | 200 | n.d. |
| ZnO NPs-GABA/CurBF2-AgNPs | ≤6.25 | 12.5 |
| Gentamicin | 4 | 4 |
Publisher’s Note: MDPI stays neutral with regard to jurisdictional claims in published maps and institutional affiliations. |
© 2021 by the authors. Licensee MDPI, Basel, Switzerland. This article is an open access article distributed under the terms and conditions of the Creative Commons Attribution (CC BY) license (http://creativecommons.org/licenses/by/4.0/).
Share and Cite
Talodthaisong, C.; Plaeyao, K.; Mongseetong, C.; Boonta, W.; Srichaiyapol, O.; Patramanon, R.; Kayunkid, N.; Kulchat, S. The Decoration of ZnO Nanoparticles by Gamma Aminobutyric Acid, Curcumin Derivative and Silver Nanoparticles: Synthesis, Characterization and Antibacterial Evaluation. Nanomaterials 2021, 11, 442. https://doi.org/10.3390/nano11020442
Talodthaisong C, Plaeyao K, Mongseetong C, Boonta W, Srichaiyapol O, Patramanon R, Kayunkid N, Kulchat S. The Decoration of ZnO Nanoparticles by Gamma Aminobutyric Acid, Curcumin Derivative and Silver Nanoparticles: Synthesis, Characterization and Antibacterial Evaluation. Nanomaterials. 2021; 11(2):442. https://doi.org/10.3390/nano11020442
Chicago/Turabian StyleTalodthaisong, Chanon, Kittiya Plaeyao, Chatariga Mongseetong, Wissuta Boonta, Oranee Srichaiyapol, Rina Patramanon, Navaphun Kayunkid, and Sirinan Kulchat. 2021. "The Decoration of ZnO Nanoparticles by Gamma Aminobutyric Acid, Curcumin Derivative and Silver Nanoparticles: Synthesis, Characterization and Antibacterial Evaluation" Nanomaterials 11, no. 2: 442. https://doi.org/10.3390/nano11020442
APA StyleTalodthaisong, C., Plaeyao, K., Mongseetong, C., Boonta, W., Srichaiyapol, O., Patramanon, R., Kayunkid, N., & Kulchat, S. (2021). The Decoration of ZnO Nanoparticles by Gamma Aminobutyric Acid, Curcumin Derivative and Silver Nanoparticles: Synthesis, Characterization and Antibacterial Evaluation. Nanomaterials, 11(2), 442. https://doi.org/10.3390/nano11020442

